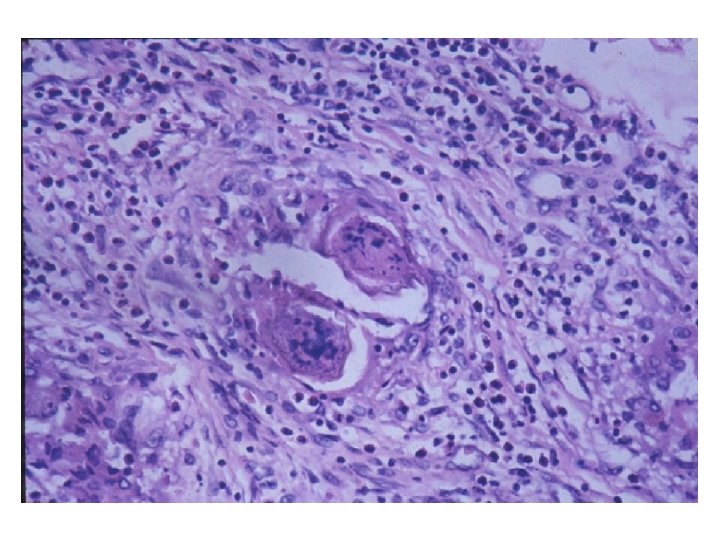

Imunidade e imunopatologia nas doenas infecciosas Hiro Goto























































- Slides: 55

Imunidade e imunopatologia nas doenças infecciosas Hiro Goto Laboratório de Soroepidemiologia e Imunobiologia do Instituto de Medicina Tropical de São Paulo Departamento de Medicina Preventiva da FMUSP

Nas infecções, a doença se manifesta por falha na resposta imune? Como o microrganismo sobrevive na presença de resposta imune? A resposta imune só atua na proteção? A resposta imune pode ser responsável pelas manifestações patológicas nas infecções?


Alguns patógenos causadores de doenças no homem





IMUNIDADE INATA Primeira linha de defesa contra organismos patogênicos

IMUNIDADE INATA: BARREIRAS NATURAIS Área da pele: 2 metros quadrados Massa de microrganismos no intestino: 2 - 3 quilos


IMUNIDADE INATA: INTERAÇÕES MOLECULARES vesículas toxinas Bactérias extracelulares Interação com NLR

RESPOSTA INATA: EFEITOS • Inicia o burst oxidativo • Produção de pepetídeos antimicrobianos • Produção de citocinas pró-inflamatórias que alertam outras células para a infecção • Recrutamento de outras células • Induz resposta sistêmica como febre • Ativação do sistema complemento • Resposta inata e a presença do antígeno leva à indução da resposta imune adaptativa

IMUNIDADE ADAPTATIVA NA AÇÃO ANTIMICROBIANA A regra não é absoluta


IMUNIDADE ADAPTATIVA: MEMÓRIA IMUNOLÓGICA

RESPOSTA IMUNE PRIMÁRIA E SECUNDÁRIA Na resposta secundária ocorre: • Aumento da quantidade • Melhora na qualidade (maturação da afinidade) • Mudança de isótipo (Ig. M para Ig. G, Ig. M para Ig. A, Ig. M para Ig. E, etc. )


IMUNOPATOLOGIA Resposta imune leva a lesões Hipersensibilidade = resposta imune que leva a lesão tecidual

Hipersensibilidade Tipo II Tipo I anticorpos Ig. G ou Ig. M anticorpos Ig. E alérgeno fagocitos celula K mastócito enzimas Fce R lesao anticorpos Ig. G Tipo III lesao ADCC mediadores Mf Ag membrana MAC C 3 b Fc. R CR lesao complemento imunocomplexos soluveis PMN citocinas Ba aminas vasoativas Fc. R C 3 a. C 5 a complemento enzimas plaquetas

Hipersensibilidade tipo IV linfocitos T CD 4+ ou CD 8+ APC T citotóxico CTL citocinas enzimas Mf perforina Inflamação quimiocinas

IMUNIDADE A BACTÉRIAS EXTRACELULARES

IMUNIDADE A BACTÉRIAS EXTRACELULARES Imunidade resultando em cura Pneumonia por Streptococcus pneumoniae Cura quando o anticorpo antipolissacarídeo da cápsula da bactéria atinge níveis elevados Imunidade resultando em lesão a distância Faringite ou impetigo por Streptococcus beta- hemoítico nefritogênico Indução de glomerulonefrite difusa aguda

IMUNIDADE A BACTÉRIAS INTRACELULARES

IMUNIDADE A BACTÉRIAS INTRACELULARES Imunidade resultando em cura Mycobacterium tuberculosis Rx de tórax mostrando calcificação no hilo pulmonar esquerdo após cura da tuberculose primária Alteração da resposta imune resultando em lesão Mycobacterium leprae pólo tuberculóide pólo lepromatoso M. tuberculosis Granuloma pulmonar

IMUNIDADE A VÍRUS

IMUNIDADE A VÍRUS

IMUNIDADE A VÍRUS Imunidade resultando em cura Sarampo Primeira infecção Existe segundo episódio de sarampo?

IMUNIDADE A VÍRUS Alteração da resposta imune resultando em manifestação patológica - AIDS

IMUNIDADE A FUNGOS

IMUNIDADE A FUNGOS Imunidade e tratamento resultando em cura Alteração da resposta imune resultando em lesão Paracoccidioides brasiliensis

IMUNIDADE A PARASITOS PECULARIEDADE DA INFECÇÃO POR PARASITOS Tempo de replicação relativamente longo Necessidade de permanência de maior tempo do parasito dentro do hospedeiro para possibilitar a transmissão Evasão do parasito Modulação da resposta imune do hospedeiro


Sistema imune reconhece o parasito? Schistosoma spp • Vermes não se multiplicam no hospedeiro • Ovos – produção • Ovos nos tecidos patologia

üPresença de várias espécies numa mesma área üCiclo eritrocítico – 48 – 72 h (1 32) • • • Encobrimento de imunógeno importante na superfície de esporozoito por CSP Escape para dentro de hemácias (não expressa MHC) Diferentes antígenos para diferentes fases do ciclo Defeito na apresentação de antígeno Imunossupressão

Trypanosoma brucei Anticorpos não são eficientes?


Trypanosoma cruzi



Formas clínicas de leishmanioses Leishmaniose visceral Leishmaniose cutânea Leishmaniose mucocutânea

Burst oxidativo Lise Evasão

Suscetibilidade


PECULIARIDADE DA INFECÇÃO POR PARASITOS Tempo de replicação relativamente longo Evasão do parasito Modulação da resposta imune do hospedeiro Consegue permanência por tempo maior do parasito dentro do hospedeiro Resposta imune mantém-se ativa Lesões são provocadas pela resposta imune

Nas doenças infecciosas humanas muitas lesões ocorrem por mecanismos de hipersensibilidade